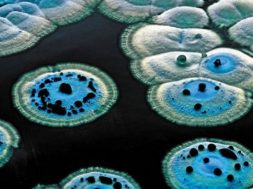

Αντιβιοτικά και τροχαία, δυο φλέγοντα ζητήματα
Τα αντιβιοτικά και τα τροχαία αποτελούν δύο φλέγοντα ζητήματα της ελληνικής πραγματικότητας. Η χώρα μας έχει τη θλιβερή πρωτιά σε κατανάλωση αντιβιοτικών και σε θανάτους από τροχαία, όπως επισημάνθηκε στη διάρκεια συνέντευξης Τύπου, ενόψει των 16ου Πανελλήνιου Συνεδρίου Χειρουργικών Λοιμώξεων και 8oυ Πανελλήνιου Συνεδρίου Τραύματος & Επείγουσας Χειρουργικής με θέμα: «Τραύμα – Λοίμωξη – Σήψη» που διεξήχθη 3-6 Οκτωβρίου στη Θεσσαλονίκη στο Lazart Hotel.
“ Πριν 40 χρόνια είπαν ότι με τη χρήση των αντιβιοτικών ήρθε το τέλος των μικροβίων. Και τώρα μιλάμε για το τέλος των αντιβιοτικών γιατί λόγω της κατάχρησης τα μικρόβια ανέπτυξαν πολυανθεκτικά στελέχη και έχουμε λοιμώξεις οι οποίες σκοτώνουν” επισήμανε πρόεδρος της Οργανωτικής Επιτροπής του συνεδρίου, καθηγητής Χειρουργικής του ΑΠΘ και διευθυντής της Ε’ Χειρουργικής Κλινικής του Ιπποκράτειου Νοσοκομείου Θεσσαλονίκης, Απόστολος Καμπαρούδης.
Παράλληλα έδωσε το μήνυμα ότι: τα αντιβιοτικά δεν είναι αντιπυρετικά, δεν είναι αναλγητικά, δεν έχουν δράση απέναντι στους ιούς, δεν κάνουν κακό μόνο σε αυτόν που τα παίρνει αλόγιστα αλλά και στα πρόσωπα του περιβάλλοντός του. “ Τα αντιβιοτικά δεν είναι καραμέλες, είναι φάρμακα και ως φάρμακα έχουν και σοβαρές παρενέργειες και συνέπειες” πρόσθεσε ο κ. Καμπαρούδης τονίζοντας ότι για την υπερκατανάλωση αντιβιοτικών ευθύνονται και οι γιατροί και οι φαρμακοποιοί επειδή δεν κάνουν σωστές συστάσεις στους ασθενείς. Κι επειδή δεν πρόκειται να κυκλοφορήσουν νέα αντιβιοτικά τα επόμενα χρόνια και ίσως μόνο βελτιωθεί η σύστασή τους , όπως είπε , εκείνο που πρέπει να κάνουμε είναι να αλλάξουμε την αντοχή των μικροβίων μειώνοντας τη χρήση αντιβιοτικών.
Η Ελλάδα μαζί με την Ιταλία έχουν τους περισσότερους θανάτους από πολυανθεκτικά μικρόβια. Το 37% αυτών που προβάλλονται από πολυανθεκτικά μικρόβια πεθαίνουν,οι περισσότεροι στις Μονάδες Εντατικής Θεραπείας, γι αυτό θα πρέπει να λάβουμε μέτρα, υπογράμμισε ο πρόεδρος της Ελληνικής Εταιρείας Χειρουργικών Λοιμώξεων, αναπληρωτής καθηγητής Χειρουργικής του ΑΠΘ, Ιωάννης Κουτελιδάκης.
Οσον αφορά τα τροχαία, ο πρόεδρος της Ελληνικής Εταιρείας Τραύματος και Επείγουσας Χειρουργικής, καθηγητής Χειρουργικής του Πανεπιστημίου Θεσσαλίας, Κωνσταντίνος Τεπετές, επισήμανε ότι στη χώρα μας κάθε χρόνο χάνουν τη ζωή τους 2.000-.3.000 άνθρωποι παραγωγικής ηλικίας, ενώ σε κάθε νεκρό αντιστοιχούν τρία περιστατικά μόνιμης αναπηρίας.
“ Τα τελευταία 50 χρόνια 150.000 άτομα, δηλαδή όσο ο πληθυσμός του Βόλου, σκοτώθηκαν στους δρόμους. Είναι η μεγαλύτερη απώλεια ζωών μετά τον Β΄Παγκόσμιο Πόλεμο” είπε ο κ.Τεπετές και πρόσθεσε ότι για τα τροχαία δεν ευθύνονται τόσο οι δρόμοι και τα οχήματα, όσο η οδική συμπεριφορά των πολιτών είτε αυτοί είναι οδηγοί κάθε είδους οχημάτων είτε είναι πεζοί.